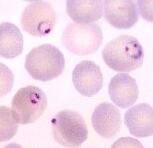
Leuconeu.jpg

Leucocitos neutrófilos
Leucocitos neutrófilos. Es el aumento de los leucocitos( Glóbulos blancos) por encima de los limites normales( Hasta 10.000 en no fumadores hasta 12.000 en fumadores) hay varios tipos de glóbulos blancos , neutrofilos , linfocitos, monocitos eosinofilos y basofilos. La neutrofilia es el aumento de los neutrofilos , la causa mas común son las infecciones.
Cuando se habla de Neutrofilia es que hay un aumento en los Neutrófilos, y se encuentra muy relacionado con infecciones de tipo bacteriana, aunque hay situaciones normales en que se pueden aumentar, como lo son el estrés, embarazo, ejercicio; algunos medicamentos también pueden ocasinarla o en casos de inflamación.
Sumario
Causas de neutrofilia
- Fisiológicas: Ejercicio, estrés, embarazo, parto, calor/frío, tabaquismo. Embarazo (tercer trimestre), parto y puerperio, infancia (en el recién nacido 25.000 o más y en el niño de 12.000 a 14.000), esfuerzo, emociones intensas, calor.
- Infecciones: Bacterianas, micobacterias, tifus, espiroquetas, virus. Otras enfermedades fusoepirilares, ricketsiosis, complicaciones sépticas, micosis diseminadas, complicaciones bacterianas de las virosis.
- Inflamación/ Necrosis: Infarto agudo de miocardio, quemaduras, conectivopatías, peritonitis, colitis…
- Tumores: Gástrico, mama, broncógeno, metástasis. Linfoma, mieloma múltiple, policitemia vera, leucemia mieloide crónica
- Fármacos: Digital, corticoides, heparina, AINE, litio.
- Fisiológicas
- No infecciosas
- Hematológicas: Posthemorragica por la anoxia que estimula la medula ósea, esplenectomizados, en las anemias hemolítica, en la policitemia, hipovolemia, hemoconcentración, deshidratación. *Reactivas: Dolor intenso, estrés físico o emocional, cetoacidosis diabética, quemaduras, necrosis, traumatismos, abdomen agudo, cólico nefrítico, perforación víscera hueca, el infarto agudo de miocardio, postoperatorio, estado agónico o preagónico, en el coma.*Neoplásicas: Reucemias, leucemias mieloides, síndrome mielodispásico, enfermedades mieloproliferativas, policitemia vera, tumores malignos, metástasis óseas.*Tóxicas: Fármacos, gota (acumulación de ácido úrico), acidosis urémica/diabética, catecolaminas, vacunas, litio, corticoides, hipoxia.
Etiología
• Mononucleosis infecciosa: Hay leucocitosis con linfocitosis atípica y serología positiva para virus Epstein-Barr (EBV).
- Linfocitosis infecciosa aguda: se trata de linfocitos maduros.
- Tos ferina
Sepsis: Elevación de la serie mieloide.
- Neoplasias con metástasis óseas
- Síndrome hipereosinofilico.
- Anemias agudas
Diagnóstico diferencial con las leucemias
- Fosfatasa alcalina leucocitaria aumentada (en la RL)
- Cromosoma Philadelphia ausente en la RL
- Estudios de médula ósea en casos dudosos.
- Pueden presentar formas inmaduras periféricas, pero casi nunca blastos.
- Menos de 70.000 leucocitos
Recuentos celulares hematológicos
- Monocitosis. Se refiere al aumento absoluto de los monocitos en la sangre periférica por encima de 700 por mm3. Las causas más comunes son:
- Infecciones bacterianas: Endocarditis bacteriana, sífilis, brucelosis y tuberculosis (es interesante recordar que los fosfolípidos que recubren el bacilo de Koch son desdoblados dentro del monocito y éste se transformar en la célula epiteloide del granuloma).
- Viral: Mononucleosis infecciosa.
- Enfermedades hematológicas: síndromes mielodisplásicos, leucemia monocítica aguda y mielomonocítica crónica, enfermedad de Hodgkin, en la fase de recuperación de una neutropenia y estado post-esplenectomía.
- Neoplasias: cáncer de ovario, estómago y mama
- Otras: Enfermedades del tejido conectivo, esprúe, enteritis regional y colitis ulcerosa crónica.
El médico extrae la sangre de la vena y la recoge en un recipiente hermético. En los bebés o niños pequeños, la sangre se toma de una punción en el talón o en el dedo de la mano y se recoge en un pequeño tubo de vidrio, sobre un portaobjetos o sobre una tira reactiva. Se puede aplicar un algodón o un vendaje para detener cualquier sangrado. Un especialista del laboratorio toma una gota de sangre de la muestra y la extiende sobre un portaobjetos de vidrio. La extensión se tiñe con un tinte especial, el cual ayuda a establecer la diferencia entre diversos tipos de glóbulos blancos. Normalmente, aparecen cinco tipos de glóbulos blancos, también llamados leucocitos, en la sangre:
- Neutrófilos
- Linfocitos (Células B y T)
- Monocitos
- Eosinófilos
- Basófilos
Una computadora o el médico cuenta el número de cada tipo de célula. El examen muestra si el número de células está en la proporción apropiada entre sí y si hay más o menos cantidad de un tipo de célula.
Extraer una muestra de sangre implica muy poco riesgo. Las venas y las arterias varían en tamaño de un paciente a otro y de un lado del cuerpo a otro, razón por la cual extraer sangre de algunas personas puede ser más difícil que de otras. Otros riesgos asociados con la extracción de sangre son leves, pero pueden ser:
- Sangrado excesivo
- Desmayo o sensación de mareo
- Hematoma (acumulación de sangre debajo de la piel)
Infección (un riesgo leve cada vez que se presenta ruptura de la piel)
Problemas y Posibles Riesgos
- La obtención mediante un pinchazo de la vena puede producir cierto dolor.
- La posible dificultad en encontrar la vena apropiada puede dar lugar a varios pinchazos.
- Aparición de un hematoma (moratón o cardenal) en la zona de extracción; suele deberse a que la vena no se ha cerrado bien tras la presión posterior y ha seguido saliendo sangre produciendo este problema. Puede aplicarse una pomada tipo Hirudoid® o Trombocid® en la zona.
- Inflamación de la vena (flebitis); a veces la vena se ve alterada, bien sea por una causa meramente física o por que se ha infectado. Se deberá mantener la zona relajada unos días y se puede aplicar una pomada tipo Hirudoid® o Trombocid® en la zona. Si el problema persiste o aparece fiebre deberá consultarlo con su médico.